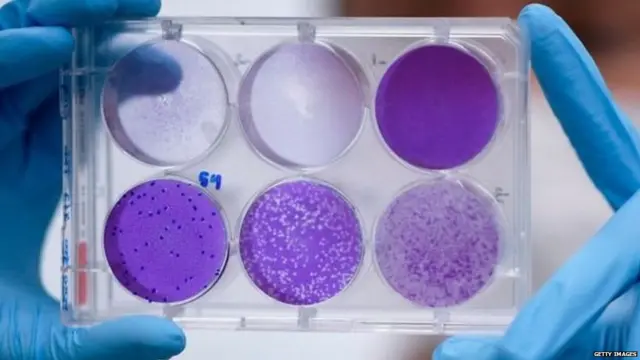
ਕੋਰੋਨਾਵਾਇਰਸ

ਕੋਰੋਨਾਵਾਇਰਸ: ਪਹਿਲਾਂ ਵੀ ਤਬਾਹੀ ਮਚਾ ਚੁੱਕੇ ਕੋਰੋਨਾ ਲਈ ਟੀਕਾ ਕਿਉਂ ਨਹੀਂ ਬਣ ਸਕਿਆ

ਤਸਵੀਰ ਸਰੋਤ, ANNA GROVE PHOTOGRAPHY
- ਲੇਖਕ, ਮਾਰੀਆ ਐਲੀਨਾ ਨਵਾਸ
- ਰੋਲ, ਬੀਬੀਸੀ ਨਿਊਜ਼
- ਪੜ੍ਹਨ ਦਾ ਸਮਾਂ: 7 ਮਿੰਟ
ਸਾਲ 2002 ਵਿੱਚ ਚੀਨ ਦੇ ਗਵਾਇੰਝੋ ਸੂਬੇ ਵਿੱਚ ਇੱਕ ਅਣਪਛਾਤੇ ਵਾਇਰਸ ਕਾਰਨ ਸਾਰਸ ਮਹਾਂਮਰੀ ਫੈਲ ਗਈ ਸੀ।
ਸਾਰਸ ਦਾ ਮਤਲਬ ਸੀ ਸੀਵੀਅਰ ਅਕਿਊਟ ਰੈਸਪੀਰੇਟਰੀ ਸਿੰਡਰੌਮ। ਜਿਸ ਦਾ ਮਤਲਬ ਸੀ ਸਾਹ ਦੀ ਇੱਕ ਬੀਮਾਰੀ।
ਪਿੱਛੋਂ ਜਾ ਕੇ ਸਾਇੰਸਦਾਨਾਂ ਨੂੰ ਇਲਮ ਹੋਇਆ ਕਿ ਇਹ ਬੀਮਾਰੀ ਕਰਨ ਵਾਲਾ ਵਾਇਰਸ ਕੋਰੋਨਾ ਵਾਇਰਸ ਹੈ। ਜੋ ਸੰਭਾਵੀ ਤੌਰ 'ਤੇ ਜਾਨਵਰਾਂ ਵਿੱਚੋਂ ਇਨਸਾਨਾਂ ਵਿੱਚ ਆਇਆ ਹੈ।
ਕੁਝ ਹੀ ਸਮੇਂ ਵਿੱਚ ਵਾਇਰਸ ਦੁਨੀਆਂ ਦੇ 29 ਮੁਲਕਾਂ ਵਿੱਚ ਫ਼ੈਲ ਗਿਆ ਅਤੇ 8000 ਤੋਂ ਵਧੇਰੇ ਲੋਕਾਂ ਨੂੰ ਬੀਮਾਰ ਕਰਕੇ ਲਗਭਗ 800 ਜਣਿਆਂ ਨੂੰ ਕਾਲ ਦੇ ਗ੍ਰਾਸ ਬਣਾ ਗਿਆ।
ਉਸ ਸਮੇਂ ਭੜਥੂ ਪਿਆ ਸੀ ਕਿ ਇਸ ਦੀ ਵੈਕਸੀਨ ਕਦੋਂ ਤੱਕ ਆਵੇਗੀ। ਦੁਨੀਆਂ ਭਰ ਦੇ ਸਾਇੰਸਦਾਨ ਖੋਜ ਵਿੱਚ ਲੱਗ ਗਏ।
ਕਈ ਲੋਕ ਮੈਦਾਨ ਵਿੱਚ ਆਏ ਉਨ੍ਹਾਂ ਨੇ ਕਿਹਾ ਕਿ ਉਹ ਆਪਣੇ ਵੱਲੋਂ ਤਿਆਰ ਵੈਕਸੀਨਾਂ ਦੇ ਕਲੀਨੀਕਲ ਟਰਾਇਲਜ਼ ਲਈ ਤਿਆਰ ਹਨ।
ਇਸ ਲੇਖ ਵਿੱਚ Google YouTube ਤੋਂ ਮਿਲੀ ਸਮੱਗਰੀ ਸ਼ਾਮਲ ਹੈ। ਕੁਝ ਵੀ ਡਾਊਨਲੋਡ ਹੋਣ ਤੋਂ ਪਹਿਲਾਂ ਅਸੀਂ ਤੁਹਾਡੀ ਇਜਾਜ਼ਤ ਮੰਗਦੇ ਹਾਂ ਕਿਉਂਕਿ ਇਸ ਵਿੱਚ ਕੁਕੀਜ਼ ਅਤੇ ਦੂਜੀਆਂ ਤਕਨੀਕਾਂ ਦਾ ਇਸਤੇਮਾਲ ਕੀਤਾ ਹੋ ਸਕਦਾ ਹੈ। ਤੁਸੀਂ ਸਵੀਕਾਰ ਕਰਨ ਤੋਂ ਪਹਿਲਾਂ Google YouTube ਕੁਕੀ ਪਾਲਿਸੀ ਤੇ ਨੂੰ ਪੜ੍ਹਨਾ ਚਾਹੋਗੇ। ਇਸ ਸਮੱਗਰੀ ਨੂੰ ਦੇਖਣ ਲਈ ਇਜਾਜ਼ਤ ਦੇਵੋ ਤੇ ਜਾਰੀ ਰੱਖੋ ਨੂੰ ਚੁਣੋ।
End of YouTube post, 1
ਵੈਕਸੀਨ ਦੀ ਲੋੜ
ਉਸੇ ਦੌਰਾਨ ਮਹਾਂਮਾਰੀ ਉੱਪਰ ਕਾਬੂ ਪਾ ਲਿਆ ਗਿਆ ਅਤੇ ਜਾਰੀ ਖੋਜ ਦਾ ਕੰਮ ਠੱਪ ਹੋ ਗਿਆ।
ਕੁਝ ਸਾਲਾਂ ਬਾਅਦ ਇਸੇ ਕੋਰੋਨਾ ਵਾਇਰਸ ਪਰਿਵਾਰ ਦੇ ਇੱਕ ਹੋਰ ਵਾਇਰਸ ਨੇ ਮਰਸ-ਕੋਵ (ਮਿਡਲ ਈਸਟ ਰੈਸਪੀਰੇਟਰੀ ਸਿੰਡਰੋਮ) ਦਾ ਕਹਿਰ ਢਾਹਿਆ। ਇਹ ਵਾਇਰਸ ਉੱਠਾਂ ਤੋਂ ਮਨੁੱਖਾਂ ਵਿੱਚ ਆਇਆ ਸੀ।

- ਕੋਰੋਨਾਵਾਇਰਸ ਤੋਂ ਬਚਣ ਲਈ ਸਾਨੂੰ ਕੀ-ਕੀ ਕਰਨ ਦੀ ਲੋੜ ਹੈ
- ਕੋਰੋਨਾਵਾਇਰਸ ਕਿਵੇਂ ਫੈਲਦਾ ਹੈ, ਇਸਦੇ ਲੱਛਣ ਕੀ ਹਨ ਅਤੇ ਬਚਾਅ ਦੇ ਤਰੀਕੇ
- ਕੋਰੋਨਾਵਾਇਰਸ: ਕੀ ਕੋਰੋਨਾਵਾਇਰਸ ਦਾ ਕੋਈ ਇਲਾਜ ਹੈ? - ਜਾਣੋ 13 ਮੁੱਖ ਸਵਾਲਾਂ ਦੇ ਜਵਾਬ
- ਕੋਰੋਨਾਵਾਇਰਸ: ਸੋਸ਼ਲ ਮੀਡੀਆ 'ਤੇ ਕੁਝ ਵੀ ਸ਼ੇਅਰ ਕਰਨ ਤੋਂ ਪਹਿਲਾਂ 7 ਗੱਲਾਂ ਵੱਲ ਧਿਆਨ ਦਿਓ
- ਕੋਰੋਨਾਵਾਇਰਸ: ਸਮਾਨ ਖਰੀਦਦੇ ਸਮੇਂ ਇਨ੍ਹਾਂ ਗੱਲਾਂ ਦਾ ਧਿਆਨ ਰੱਖੋ

ਸਾਇੰਸਦਾਨਾਂ ਨੇ ਇੱਕ ਵਾਰ ਮੁੜ ਇਸ ਦੀ ਵੈਕਸੀਨ ਤਿਆਰ ਕਰਨ ਦੀ ਲੋੜ ਵੱਲ ਵਿਸ਼ਵ ਭਾਈਚਾਰੇ ਦੀ ਧਿਆਨ ਦਵਾਇਆ।
ਹੁਣ ਲਗਭਗ 20 ਸਾਲਾਂ ਬਾਅਦ ਇਸੇ ਪਰਿਵਾਰ ਦੇ SARS-Cov-2 ਨੇ ਲਗਭਗ 15 ਲੱਖ ਲੋਕਾਂ ਨੂੰ ਲਾਗ਼ ਲਾਈ ਹੈ। ਹੁਣ ਦੁਨੀਆਂ ਫਿਰ ਪੁੱਛ ਰਹੀ ਹੈ ਦਵਾਈ ਕਦੋਂ ਬਣੇਗੀ।
ਕੋਰੋਨਾਵਾਇਰਸ ਦੇ ਹਮਲੇ ਦੀਆਂ ਪਿਛਲੀਆਂ ਘਟਨਾਵਾਂ ਤੋਂ ਅਸੀਂ ਕੋਈ ਸਬਕ ਨਹੀਂ ਸਿੱਖਿਆ। ਜਦਕਿ ਚੰਗੀ ਤਰ੍ਹਾਂ ਪਤਾ ਸੀ ਕਿ ਕੋਵਿਡ-19 ਵਰਗੀ ਜਾਨਲੇਵਾ ਬੀਮਾਰੀ ਹੋ ਸਕਦੀ ਹੈ।
ਅਜਿਹੇ ਵਿੱਚ ਖੋਜ-ਕਾਰਜ ਨੂੰ ਅੱਗੇ ਕਿਉਂ ਨਹੀਂ ਵਧਾਇਆ ਗਿਆ?

ਤਸਵੀਰ ਸਰੋਤ, Getty Images
‘ਸਾਨੂੰ ਦਿਲਚਸਪੀ ਨਹੀਂ ਹੈ’
ਖ਼ੈਰ ਇਸ ਦੌਰਾਨ ਅਮਰੀਕਾ ਦੇ ਹਿਊਸਟਨ ਵਿੱਚ ਸਾਇੰਸਦਾਨਾਂ ਨੇ ਇਸ ਉੱਪਰ ਕੰਮ ਕਰਨਾ ਜਾਰੀ ਰੱਖਿਆ।
ਸਾਲ 2006 ਵਿੱਚ ਉਹ ਆਪਣੇ ਯਤਨਾਂ ਵਿੱਚ ਸਫ਼ਲ ਹੋ ਗਏ ਅਤੇ ਦਵਾਈ ਤਿਆਰ ਕਰ ਲਈ।
ਬੇਯਲਰ ਕਾਲਜ ਆਫ਼ ਮੈਡੀਸਨ ਦੇ ਨੈਸ਼ਨਲ ਸਕੂਲ ਆਫ਼ ਟਰੌਪੀਕਲ ਮੈਡੀਸਨਜ਼ ਦੀ ਸਹਿ-ਨਿਰਦੇਸ਼ਕ ਮਾਰੀਆ ਐਲੀਨਾ ਬੋਟਾਜ਼ੀ ਨੇ ਬੀਬੀਸੀ ਮੁੰਡੋ ਸੇਵਾ ਨਾਲ ਇਸ ਬਾਰੇ ਗੱਲਬਾਤ ਕੀਤੀ।
ਇਸ ਲੇਖ ਵਿੱਚ Google YouTube ਤੋਂ ਮਿਲੀ ਸਮੱਗਰੀ ਸ਼ਾਮਲ ਹੈ। ਕੁਝ ਵੀ ਡਾਊਨਲੋਡ ਹੋਣ ਤੋਂ ਪਹਿਲਾਂ ਅਸੀਂ ਤੁਹਾਡੀ ਇਜਾਜ਼ਤ ਮੰਗਦੇ ਹਾਂ ਕਿਉਂਕਿ ਇਸ ਵਿੱਚ ਕੁਕੀਜ਼ ਅਤੇ ਦੂਜੀਆਂ ਤਕਨੀਕਾਂ ਦਾ ਇਸਤੇਮਾਲ ਕੀਤਾ ਹੋ ਸਕਦਾ ਹੈ। ਤੁਸੀਂ ਸਵੀਕਾਰ ਕਰਨ ਤੋਂ ਪਹਿਲਾਂ Google YouTube ਕੁਕੀ ਪਾਲਿਸੀ ਤੇ ਨੂੰ ਪੜ੍ਹਨਾ ਚਾਹੋਗੇ। ਇਸ ਸਮੱਗਰੀ ਨੂੰ ਦੇਖਣ ਲਈ ਇਜਾਜ਼ਤ ਦੇਵੋ ਤੇ ਜਾਰੀ ਰੱਖੋ ਨੂੰ ਚੁਣੋ।
End of YouTube post, 2
ਉਨ੍ਹਾਂ ਨੇ ਦੱਸਿਆ, “ਅਸੀਂ ਟਰਾਇਲਜ਼ ਮੁਕਾਅ ਲਏ ਸਨ ਅਤੇ ਵੈਕਸੀਨ ਦੇ ਸ਼ੁਰੂਆਤੀ ਉਤਪਾਦਨ ਪ੍ਰਕਿਰਿਆ ਦੇ ਮਹੱਤਵਪੂਰਣ ਪੜਾਅ ਵਿੱਚੋਂ ਲੰਘ ਚੁਕੇ ਸੀ।”
ਉਨ੍ਹਾਂ ਨੇ ਦੱਸਿਆ, “ਫਿਰ ਅਸੀਂ ਐੱਨਐੱਚਆਈ (ਯੂਐੱਸ ਨੈਸ਼ਨਲ ਇੰਸਟੀਚਿਊਟ ਆਫ਼ ਹੈਲਥ) ਕੋਲ ਗਏ ਅਤੇ ਪੁੱਛਿਆ ਕਿ ‘ਵੈਕਸੀਨ ਨੂੰ ਕਲੀਨੀਕ ਤੱਕ ਜਲਦੀ ਪਹੁੰਚਾਉਣ ਲਈ ਕੀ ਕਰ ਸਕਦੇ ਹਾਂ? ਉਨ੍ਹਾਂ ਦਾ ਜਵਾਬ ਸੀ, ‘ ਦੇਖੋ, ਫ਼ਿਲਹਾਲ ਸਾਨੂੰ ਇਸ ਵਿੱਚ ਦਿਲਚਸਪੀ ਨਹੀਂ’ ਹੈ।”
ਜਦੋਂ ਇਹ ਮਹਾਂਮਾਰੀ ਮੁੱਕ ਗਈ...
ਇਹ ਟੀਕਾ ਸਾਲ 2002 ਵਿੱਚ ਫ਼ੈਲੀ ਸਾਰਸ ਮਹਾਂਮਾਰੀ ਲਈ ਤਿਆਰ ਕੀਤਾ ਗਿਆ ਸੀ। ਕਿਉਂਕਿ ਜਿਸ ਦੇਸ਼ (ਚੀਨ)ਵਿੱਚੋਂ ਇਸ ਦੀ ਸ਼ੁਰੂਆਤ ਹੋਈ ਸੀ, ਉੱਥੇ ਹੀ ਇਸ ਉੱਪਰ ਕਾਬੂ ਪਾ ਲਿਆ ਗਿਆ। ਜਿਸ ਕਾਰਨ ਸਾਇੰਸਦਾਨ ਇਸ ਉੱਪਰ ਕੰਮ ਕਰਨ ਲਈ ਪੈਸਾ ਨਾ ਜੁਟਾ ਸਕੇ।
ਅਜਿਹਾ ਨਹੀਂ ਕਿ ਸਿਰਫ਼ ਕੋਰੋਨਾਵਾਇਰਸ ਦਾ ਹੀ ਕੰਮ ਰੋਕਿਆ ਗਿਆ।

- ਕੋਰੋਨਾਵਾਇਰਸ: ਪੰਜਾਬ ਦੇ ਪਿੰਡਾਂ ਦੀਆਂ ਸੱਥਾਂ ਸੁੰਨੀਆਂ, ਪਹਿਰੇ ਲਈ ਜਦੋਂ ਔਰਤਾਂ ਸਾਹਮਣੇ ਆਈਆਂ
- ਕੋਰੋਨਾਵਾਇਰਸ: ਜਲੰਧਰ 'ਚ ਜਦੋਂ ਲੋਕ ਮ੍ਰਿਤਕ ਦਾ ਸਸਕਾਰ ਨਾ ਕਰਨ ਦੇਣ 'ਤੇ ਅੜੇ
- ਪੰਜਾਬ 'ਚ ਵੀ ਮਾਸਕ ਪਾਉਣਾ ਲਾਜ਼ਮੀ, ਕੋਰੋਨਾਵਾਇਰਸ ਪੀੜਤ ਚੋਰ ਨੂੰ ਫੜਨ ਵਾਲੇ 17 ਪੁਲਿਸ ਵਾਲੇ ਏਕਾਂਤਵਾਸ 'ਚ
- ਕੋਰੋਨਾਵਾਇਰਸ: ਕਿਸੇ ਮਰੀਜ਼ ਦਾ ICU ਵਿੱਚ ਜਾਣ ਦਾ ਕੀ ਮਤਲਬ ਹੁੰਦਾ ਹੈ?
- ਕੋਰੋਨਾਵਾਇਰਸ: ਪਲਾਜ਼ਮਾ ਥੈਰੇਪੀ ਕੀ ਹੈ ਜਿਸ ਨੂੰ ICMR ਨੇ ਮਰੀਜ਼ਾਂ ਦੇ ਇਲਾਜ ਲਈ ਪ੍ਰਵਾਨਗੀ ਦਿੱਤੀ ਹੈ

ਦੁਨੀਆਂ ਭਰ ਵਿੱਚ ਦਰਜਣਾਂ ਸਾਇੰਸਦਾਨਾਂ ਨੇ ਆਪਣੀ ਖੋਜ ਸਿਰਫ਼ ਇਸ ਲਈ ਰੋਕ ਦਿੱਤੀ ਕਿਉਂਕਿ ਲੋਕਾਂ ਦੀ ਇਸ ਵਿੱਚ ਦਿਲਚਸਪੀ ਨਹੀਂ ਰਹੀ ਸੀ ਅਤੇ ਸਾਇੰਸਦਾਨਾਂ ਨੂੰ ਪੈਸਾ ਨਹੀਂ ਸੀ ਮਿਲ ਰਿਹਾ।
ਯੂਨੀਵਰਸਿਟੀ ਆਫ਼ ਪੈਨਸਲਵੇਨੀਆ ਵਿੱਚ ਮਾਈਕ੍ਰੋਬਾਇਓਲੌਜੀ ਦੀ ਪ੍ਰੋਫ਼ੈਸਰ ਸੁਜ਼ੈਨ ਵੀਜ਼ ਕਹਿੰਦੀ ਹੈ ਕਿ ਕਿ 7-8 ਮਹੀਨਿਆਂ ਤੋਂ ਬਾਅਦ ਜਦੋਂ ਇਹ ਮਹਾਂਮਾਰੀ ਖ਼ਤਮ ਹੋ ਗਈ ਤਾਂ ਲੋਕਾਂ, ਸਰਕਾਰਾਂ ਅਤੇ ਫਾਰਮਾ ਕੰਪਨੀਆਂ ਦੀ ਕੋਰੋਨਾਵਾਇਰਸ ਦੀ ਖੋਜ ਵਿੱਚ ਦਿਲਚਸਪੀ ਖ਼ਤਮ ਹੋ ਗਈ।
ਉਹ ਕਹਿੰਦੇ ਹਨ, “ਨਾਲ ਹੀ ਸਾਰਸ ਦਾ ਅਸਰ ਏਸ਼ੀਆ ਵਿੱਚ ਜ਼ਿਆਦਾ ਦੇਖਣ ਨੂੰ ਮਿਲਿਆ। ਕੈਨੇਡਾ ਵਿੱਚ ਇਸ ਦੇ ਕੁਝ ਕੁ ਮਾਮਲੇ ਮਿਲੇ ਸਨ ਪਰ ਉਹ ਯੂਰਪ ਤੱਕ ਨਹੀਂ ਪਹੁੰਚ ਸਕਿਆ ਸੀ।
"ਜਿਵੇਂ ਕਿ ਇਸ ਵਾਰ ਕੋਰੋਨਾਵਾਇਰਸ ਨਾਲ ਹੋਇਆ ਹੈ। ਇਸ ਤੋਂ ਬਾਅਦ ਮਰਸ ਵਾਇਰਸ ਆਇਆ ਪਰ ਉਸ ਦਾ ਅਸਰ ਪੱਛਮੀ ਏਸ਼ੀਆ ਤੱਕ ਹੀ ਸੀਮਤ ਰਿਹਾ। ਫਿਰ ਕੋਰੋਨਾਵਾਇਰਸ ਵਿੱਚ ਲੋਕਾਂ ਦੀ ਦਿਲਚਸਪੀ ਖ਼ਤਮ ਹੋਣ ਲੱਗੀ।"
"ਕੁਝ ਦਿਨਾਂ ਤੱਕ ਪਹਿਲਾਂ ਵਾਲੀ ਹਾਲਤ ਰਹੀ। ਮੈਨੂੰ ਸੱਚਮੁੱਚ ਅਜਿਹਾ ਲਗਦਾ ਹੈ ਕਿ ਸਾਨੂੰ ਬਿਹਤਰ ਰੂਪ ਵਿੱਚ ਤਿਆਰ ਰਹਿਣਾ ਚਾਹੀਦਾ ਸੀ।”
ਇਸ ਲੇਖ ਵਿੱਚ Google YouTube ਤੋਂ ਮਿਲੀ ਸਮੱਗਰੀ ਸ਼ਾਮਲ ਹੈ। ਕੁਝ ਵੀ ਡਾਊਨਲੋਡ ਹੋਣ ਤੋਂ ਪਹਿਲਾਂ ਅਸੀਂ ਤੁਹਾਡੀ ਇਜਾਜ਼ਤ ਮੰਗਦੇ ਹਾਂ ਕਿਉਂਕਿ ਇਸ ਵਿੱਚ ਕੁਕੀਜ਼ ਅਤੇ ਦੂਜੀਆਂ ਤਕਨੀਕਾਂ ਦਾ ਇਸਤੇਮਾਲ ਕੀਤਾ ਹੋ ਸਕਦਾ ਹੈ। ਤੁਸੀਂ ਸਵੀਕਾਰ ਕਰਨ ਤੋਂ ਪਹਿਲਾਂ Google YouTube ਕੁਕੀ ਪਾਲਿਸੀ ਤੇ ਨੂੰ ਪੜ੍ਹਨਾ ਚਾਹੋਗੇ। ਇਸ ਸਮੱਗਰੀ ਨੂੰ ਦੇਖਣ ਲਈ ਇਜਾਜ਼ਤ ਦੇਵੋ ਤੇ ਜਾਰੀ ਰੱਖੋ ਨੂੰ ਚੁਣੋ।
End of YouTube post, 3
ਵੈਕਸੀਨ ਤਿਆਰ ਹੋ ਜਾਂਦਾ ਫਿਰ...
ਸਾਰਸ ਅਤੇ ਮਰਸ ਬਾਰੇ ਮਾਹਰਾਂ ਦਾ ਮੰਨਣਾ ਹੈ ਕਿ ਇਹ ਕੋਰੋਨਾਵਾਇਰਸ ਦੇ ਖ਼ਤਰੇ ਤੋਂ ਪਹਿਲਾਂ ਦੇ ਸੰਕੇਤ ਸਨ। ਜਿਨ੍ਹਾਂ ਨੂੰ ਨਜ਼ਰ ਅੰਦਾਜ਼ ਨਹੀਂ ਕੀਤਾ ਜਾਣਾ ਚਾਹੀਦਾ ਸੀ। ਸਗੋਂ ਖੋਜ ਜਾਰੀ ਰਹਿਣੀ ਚਾਹੀਦੀ ਸੀ।
ਹਾਲਾਂਕਿ ਡਾ਼ ਮਾਰੀਆ ਦਾ ਵੈਕਸੀਨ ਇਸ ਲਾਗ਼ ਵਿੱਚ ਕਾਰਜਸ਼ੀਲ ਕੋਰੋਨਾਵਾਇਰਸ ਲਈ ਨਹੀਂ ਸੀ। ਸਗੋਂ ਸਾਰਸ ਮਹਾਂਮਾਰੀ ਲਈ ਸੀ।
ਫਿਰ ਵੀ ਮਾਹਰ ਇਸ ਗੱਲ ਨਾਲ ਸਹਿਮਤ ਹਨ ਕਿ ਜੇ ਉਹ ਵੈਕਸੀਨ ਤਿਆਰ ਹੋ ਜਾਂਦਾ ਤਾਂ ਭਵਿੱਖ ਦੀਆਂ ਮਹਾਂਮਾਰੀਆਂ ਲਈ ਨਵੇਂ ਟੀਕੇ ਦਾ ਵਿਕਾਸ ਜ਼ਿਆਦਾ ਤੇਜ਼ ਰਫ਼ਤਾਰ ਨਾਲ ਹੋ ਸਕਣਾ ਸੀ।

ਤਸਵੀਰ ਸਰੋਤ, ANNA GROVE PHOTOGRAPHY
ਯੇਲ ਯੂਨੀਵਰਸਿਟੀ ਵਿੱਚ ਸਕੂਲ ਆਫ਼ ਪਬਲਿਕ ਹੈਲਥ ਦੇ ਪ੍ਰੋਫ਼ੈਸਰ ਜੈਸਨ ਸਕਾਰਟਰਜ਼ ਕਹਿੰਦੇ ਹਨ ਕਿ ਕੋਵਿਡ-19 ਦੀ ਮਹਾਂਮਾਰੀ ਦੇ ਖ਼ਿਲਾਫ਼ ਤਿਆਰੀਆਂ 2002 ਦੀ ਸਾਰਸ ਮਹਾਂਮਾਰੀ ਦੇ ਸਮੇਂ ਹੀ ਵਿੱਢ ਦੇਣੀਆਂ ਚਾਹੀਆਂ ਦੀਆਂ ਸਨ।
ਉਨ੍ਹਾਂ ਨੇ ਕਿਹਾ, “ਜੇ ਅਸੀਂ ਸਾਰਸ ਵੈਕਸੀਨ ਦਾ ਕੰਮ ਅੱਧਵਾਟਿਓਂ ਨਾ ਰੋਕਿਆ ਹੁੰਦਾ ਚਾਂ ਇੱਕ ਨਵੇਂ ਕੋਰੋਨਾ ਵਾਇਰਸ ਉੱਪਰ ਰਿਸਰਚ ਕਰਨ ਲਈ ਸਾਡੇ ਕੋਲ ਕੋਈ ਮੁੱਢਲੀ ਸਟੱਡੀ ਮੌਜੂਦ ਹੁੰਦੀ।”
ਕੋਰੋਨਾਵਾਇਰਸ ਦਾ ਵਿਸ਼ਾਣੂ
ਨਵਾਂ ਵਾਇਰਸ ਸਾਰਸ-ਕੋਵ-2 ਉਸੇ ਕੋਰੋਨਾਵਾਇਰਸ ਪਰਿਵਾਰ ਦਾ ਜੀਅ ਹੈ ਜਿਸ ਨੇ ਸਾਲ 2002 ਵਿੱਚ ਸਾਰਸ ਮਹਾਂਮਾਰੀ ਫ਼ੈਲਾਈ ਸੀ।
ਡਾ਼ ਮਾਰੀਆ ਮੁਤਾਬਕ ਦੋਵੇਂ ਜੱਦ ਦੇ ਪੱਖੋਂ 80 ਫ਼ੀਸਦੀ ਇੱਕੋ-ਜਿਹੇ ਹਨ।
“ਕਿਉਂਕਿ ਉਨ੍ਹਾਂ ਦੀ ਵੈਕਸੀਨ ਨੇ ਮਨਜ਼ੂਰੀ ਦੇ ਮੁਢਲੇ ਪੜਾਅ ਪਾਰ ਕਰ ਲਏ ਸਨ। ਇਸ ਲਈ ਨਵੇਂ ਵਾਇਰਸ ਦੇ ਖ਼ਿਲਾਫ਼ ਉਹ ਜਲਦੀ ਢਾਲਿਆ ਜਾ ਸਕਦਾ ਸੀ।”

- ਕੋਰੋਨਾਵਾਇਰਸ ਦੇ ਦੌਰ 'ਚ ਬੰਦਿਆਂ ਨੂੰ ਨਸੀਹਤ 'ਭਾਂਡੇ ਧੋਵੋ, ਅੱਲ੍ਹਾ-ਅੱਲ੍ਹਾ ਕਰੋ, ਰੱਬ ਆਪੇ ਖ਼ੈਰ ਕਰੇਗਾ'
- ਪੁਲਿਸ ਵਾਲੇ 'ਤੇ ਥੁੱਕਣ ਵਾਲਾ ਵੀਡੀਓ ਤੁਸੀਂ ਵੀ ਦੇਖਿਆ ਹੈ? ਹੁਣ ਇਸ ਦਾ ਸੱਚ ਵੀ ਜਾਣ ਲਵੋ
- ਕੋਰੋਨਾਵਾਇਰਸ ਦੇ ਮਰੀਜ਼ ਸਾਡੀ ਹਮਦਰਦੀ ਦੇ ਪਾਤਰ ਹਨ ਜਾਂ ਇਲਜ਼ਾਮਤਰਾਸ਼ੀ ਦੇ
- ਪੰਜਾਬ 'ਚ ਵੀ ਮਾਸਕ ਪਾਉਣਾ ਲਾਜ਼ਮੀ, ਕੋਰੋਨਾਵਾਇਰਸ ਪੀੜਤ ਚੋਰ ਨੂੰ ਫੜਨ ਵਾਲੇ 17 ਪੁਲਿਸ ਵਾਲੇ ਏਕਾਂਤਵਾਸ 'ਚ

“ਸਾਡੇ ਕੋਲ ਇਸ ਦੀਆਂ ਮਿਸਾਲਾਂ ਹੁੰਦੀਆਂ ਕਿ ਵੈਕਸੀਨ ਕਿਵੇਂ ਕੰਮ ਕਰਦਾ ਹੈ। ਸਾਡੇ ਕੋਲ ਇਸ ਗੱਲ ਦਾ ਅਨੁਭਵ ਹੁੰਦਾ ਕਿ ਸਮੱਸਿਆ ਦੀ ਜੜ੍ਹ ਕਿੱਥੇ ਹੈ ਅਤੇ ਉਸ ਨੂੰ ਕਿਵੇਂ ਹੱਲ ਕੀਤਾ ਜਾ ਸਕਦਾ ਹੈ।“
“ਕਿਉਂਕਿ ਅਸੀਂ ਪਹਿਲਾਂ ਇਹ ਦੇਖਿਆ ਸੀ ਕਿ ਕਲੀਨੀਕਲ ਟਰਾਇਲਜ਼ ਦੇ ਸ਼ੁਰੂ ਵਿੱਚ ਸਾਰਸ ਵੈਕਸੀਨ ਕਿਵੇਂ ਪ੍ਰਤੀਕਿਰਿਆ ਕਰ ਰਿਹਾ ਸੀ। ਸਾਨੂੰ ਉਮੀਦ ਹੈ ਕਿ ਨਵੀਂ ਵੈਕਸੀਨ ਵੀ ਲਗਭਗ ਉਸੇ ਤਰ੍ਹਾਂ ਕੰਮ ਕਰਦੀ।”
ਖ਼ਰਾਬ ਕਾਰੋਬਾਰੀ ਪੇਸ਼ਕਸ਼
ਜੇ ਇਹ ਸਾਰੀਆਂ ਜਾਣਕਾਰੀਆਂ ਮੌਜੂਦ ਹਨ ਤਾਂ ਉਸ ਸਮੇਂ ਕੋਰੋਨਾਵਾਇਰਸ ਉੱਪਰ ਚੱਲ ਰਹੀ ਖੋਜ ਕਿਉਂ ਰੋਕੀ ਗਈ? ਮਾਹਰਾਂ ਦਾ ਮੰਨਣਾ ਹੈ ਕਿ ਇਹ ਇਸ ਗੱਲ ਉੱਪਰ ਨਿਰਭਰ ਕਰਦਾ ਹੈ ਕਿ ਖੋਜ ਲਈ ਪੈਸਾ ਕਿੰਨਾ ਮਿਲ ਰਿਹਾ ਹੈ।
ਡਾ਼ ਮਾਰੀਆ ਕਹਿੰਦੇ ਹਨ, “ਅਸੀਂ ਸੌ ਡਾਲਰ ਜਾਂ ਇੱਕ ਅਰਬ ਡਾਲਰ ਦੀ ਗੱਲ ਨਹੀਂ ਕਰ ਰਹੇ ਹਾਂ। ਅਸੀਂ ਸਿਰਫ਼ 30 ਤੋਂ 40 ਲੱਖ ਡਾਲਰ ਦੀ ਗੱਲ਼ ਕਰ ਰਹੇ ਹਾਂ।“
ਤਸਵੀਰ ਸਰੋਤ, Getty Images
“15 ਲੱਖ ਡਾਲਰ ਵਿੱਚ ਅਸੀਂ ਇਨਸਾਨਾਂ ਉੱਪਰ ਇਸ ਵੈਕਸੀਨ ਦੇ ਅਸਰ ਦਾ ਕਲੀਨੀਕਲ ਅਧਿਐਨ ਪੂਰਾ ਕਰ ਲੈਂਦੇ। ਜਦਕਿ ਸਾਡਾ ਕੰਮ ਉਸ ਮੁਕਾਮ ਉੱਪਰ ਆ ਕੇ ਰੋਕ ਦਿੱਤਾ ਗਿਆ ਜਦੋਂ ਅਸੀਂ ਦਿਲਚਸਪ ਨਤੀਜਿਆਂ ਤੱਕ ਪਹੁੰਚਣ ਦੇ ਨੇੜੇ ਸੀ।”
ਬਾਇਓਟੈਕ ਕੰਪਨੀ ਆਰਏ ਕੈਪੀਟਲ ਦੇ ਡਾਇਰੈਕਟਰ ਅਤੇ ਵਿਸ਼ਾਣੂ- ਮਾਹਰ ਪੀਟਰ ਕੋਲਚਿੰਸਕੀ ਦੱਸਦੇ ਹਨ, “ਕਿਉਂਕਿ ਇਸ ਵੈਕਸੀਨ ਦਾ ਕੋਈ ਬਾਜ਼ਾਰ ਨਹੀਂ ਸੀ। ਇਸ ਲਈ ਇਸ ਵਾਸਤੇ ਪੈਸਾ ਦੇਣਾ ਬੰਦ ਕਰ ਦਿੱਤਾ ਗਿਆ। ਅੱਜ ਸਾਡੇ ਕੋਲ ਕੋਰੋਨਾਵਾਇਰਸ ਦੇ ਸੈਂਕੜੇ ਵੈਕਸੀਨ ਹਨ ਪਰ ਉਹ ਸਾਰੇ ਸੂਰਾ, ਮੁਰਗੇ-ਮੁਰਗੀਆਂ ਅਤੇ ਗਾਵਾਂ ਵਰਗੇ ਜਾਨਵਰਾਂ ਲਈ ਹਨ।”
ਇਹ ਉਹ ਵੈਕਸੀਨ ਹਨ ਜੋ ਪਾਲਤੂ ਜਾਨਵਰਾਂ ਦੀਆਂ ਬੀਮਾਰੀਆਂ ਲਈ ਹਨ। ਇਨ੍ਹਾਂ ਦਾ ਕਰੋੜਾਂ ਡਾਲਰ ਦਾ ਕਾਰੋਬਾਰ ਹੈ। ਫਿਰ ਵੀ ਇਹ ਸੋਚਿਆ ਗਿਆ ਕਿ ਮਨੁੱਖਾਂ ਨੂੰ ਆਪਣਾ ਸ਼ਿਕਾਰ ਬਣਾਉਣ ਵਾਲੀ ਕੋਰੋਨਾਵਾਇਰਸ ਦੀ ਮਹਾਂਮਾਰੀ ਉੱਪਰ ਕਾਬੂ ਪਾਇਆ ਜਾ ਸਕਦਾ ਹੈ।

ਪੀਟਰ ਕੋਲਚਿੰਸਕੀ ਕਹਿੰਦੇ ਹਨ, “ਸਮੱਸਿਆ ਇਹ ਹੈ ਕਿ ਕਿਸੇ ਵੀ ਕੰਪਨੀ ਲਈ ਕੋਈ ਅਜਿਹਾ ਪ੍ਰੋਜੈਕਟ ਤਿਆਰ ਇੱਕ ਖ਼ਰਾਬ ਕਾਰੋਬਾਰੀ ਪੇਸ਼ਕਸ਼ ਹੈ। ਜਿਸਦੀ ਦਹਾਕਿਆਂ ਤੱਕ ਕਿਤੇ ਵਰਤੋਂ ਹੀ ਨਹੀਂ ਕੀਤੀ ਜਾ ਸਕਣੀ। ਇਹ ਅਜਿਹੀ ਚੀਜ਼ ਹੈ ਜਿਸ ਉੱਪਰ ਸਰਕਾਰਾਂ ਨੂੰ ਪੈਸਾ ਲਾਉਣਾ ਚਾਹੀਦਾ ਹੈ। ਜੇ ਇਹ ਉਨ੍ਹਾਂ ਦੀ ਪਹਿਲਤਾ ਰਿਹਾ ਹੁੰਦਾ ਤਾਂ ਨਿਸ਼ਚੈ ਹੀ ਉਨ੍ਹਾਂ ਨੇ ਪੈਸਾ ਦੇਣਾ ਜਾਰੀ ਰੱਖਿਆ ਹੁੰਦਾ।”
ਨਵੀਂ ਵੈਕਸੀਨ
ਅੱਜ ਦਾ ਸੱਚ ਤਾਂ ਇਹੀ ਹੈ ਕਿ ਸਾਨੂੰ ਕੋਵਿਡ-19 ਲਈ ਵੈਕਸੀਨ ਚਾਹੀਦੀ ਹੈ। ਇਸ ਗੱਲ਼ ਦੀ ਸੰਭਾਵਨਾ ਘੱਟ ਰਹੀ ਹੈ ਕਿ ਆਉਣ ਵਾਲੇ 12 ਤੋਂ 18 ਮਹੀਨਿਆਂ ਵਿੱਚ ਕੋਈ ਵੈਕਸੀਨ ਆ ਸਕੇਗੀ।

ਤਸਵੀਰ ਸਰੋਤ, Getty Images
ਉਸ ਸਮੇਂ ਤੱਕ ਕੋਰੋਨਾਵਾਇਰਸ ਮਹਾਂਮਾਰੀ ਉੱਪਰ ਸ਼ਾਇਦ ਕਾਬੂ ਪਾ ਲਿਆ ਜਾਵੇ। ਡਾਕਟਰ ਮਾਰੀਆ ਅਤੇ ਉਨ੍ਹਾਂ ਦੀ ਟੀਮ 2016 ਵਿੱਚ ਤਿਆਰ ਕੀਤੇ ਗਏ ਵੈਕਸੀਨ ਨੂੰ ਅਪਗ੍ਰੇਡ ਕਰਨ ਦਾ ਕੰਮ ਕਰ ਰਹੇ ਹਨ। ਜਿਸ ਨਾਲ ਕਿ ਕੋਵਿਡ-19 ਦਾ ਨਵਾਂ ਟੀਕਾ ਬਣ ਸਕੇ। ਹਾਲੇ ਵੀ ਉਨ੍ਹਾਂ ਨੂੰ ਖੋਜ ਲਈ ਪੈਸਾ ਜੁਟਾਉਣ ਲਈ ਮੁਸ਼ਕੱਤ ਕਰਨੀ ਪੈ ਰਹੀ ਹੈ।
ਉਨ੍ਹਾਂ ਦਾ ਕਹਿਣਾ ਹੈ, “2016 ਦੀ ਵੈਕਸੀਨ ਦੇ ਅਪਡੇਟ ਦੇ ਕੰਮ ਨੂੰ ਤੇਜ਼ ਕਰਨ ਲਈ ਪੈਸਾ ਮਿਲ ਰਿਹਾ ਹੈ। ਨੈਸ਼ਨਲ ਇੰਸਟੀਚਿਊਟ ਆਫ਼ ਹੈਲਥ ਨੇ ਵੀ ਚਾਰ ਲੱਖ ਡਾਲਰ ਜਾਰੀ ਕੀਤੇ ਹਨ। ਲੇਕਿਨ ਇਹ ਪੂਰੀ ਪ੍ਰਕਿਰਿਆ ਨਿਰਾਸ਼ ਕਰਨ ਵਾਲੀ ਹੈ।”

ਤਸਵੀਰ ਸਰੋਤ, MoHFW_INDIA

ਇਹ ਵੀਡੀਓ ਦੇਖੋ
ਇਸ ਲੇਖ ਵਿੱਚ Google YouTube ਤੋਂ ਮਿਲੀ ਸਮੱਗਰੀ ਸ਼ਾਮਲ ਹੈ। ਕੁਝ ਵੀ ਡਾਊਨਲੋਡ ਹੋਣ ਤੋਂ ਪਹਿਲਾਂ ਅਸੀਂ ਤੁਹਾਡੀ ਇਜਾਜ਼ਤ ਮੰਗਦੇ ਹਾਂ ਕਿਉਂਕਿ ਇਸ ਵਿੱਚ ਕੁਕੀਜ਼ ਅਤੇ ਦੂਜੀਆਂ ਤਕਨੀਕਾਂ ਦਾ ਇਸਤੇਮਾਲ ਕੀਤਾ ਹੋ ਸਕਦਾ ਹੈ। ਤੁਸੀਂ ਸਵੀਕਾਰ ਕਰਨ ਤੋਂ ਪਹਿਲਾਂ Google YouTube ਕੁਕੀ ਪਾਲਿਸੀ ਤੇ ਨੂੰ ਪੜ੍ਹਨਾ ਚਾਹੋਗੇ। ਇਸ ਸਮੱਗਰੀ ਨੂੰ ਦੇਖਣ ਲਈ ਇਜਾਜ਼ਤ ਦੇਵੋ ਤੇ ਜਾਰੀ ਰੱਖੋ ਨੂੰ ਚੁਣੋ।
End of YouTube post, 4
ਇਸ ਲੇਖ ਵਿੱਚ Google YouTube ਤੋਂ ਮਿਲੀ ਸਮੱਗਰੀ ਸ਼ਾਮਲ ਹੈ। ਕੁਝ ਵੀ ਡਾਊਨਲੋਡ ਹੋਣ ਤੋਂ ਪਹਿਲਾਂ ਅਸੀਂ ਤੁਹਾਡੀ ਇਜਾਜ਼ਤ ਮੰਗਦੇ ਹਾਂ ਕਿਉਂਕਿ ਇਸ ਵਿੱਚ ਕੁਕੀਜ਼ ਅਤੇ ਦੂਜੀਆਂ ਤਕਨੀਕਾਂ ਦਾ ਇਸਤੇਮਾਲ ਕੀਤਾ ਹੋ ਸਕਦਾ ਹੈ। ਤੁਸੀਂ ਸਵੀਕਾਰ ਕਰਨ ਤੋਂ ਪਹਿਲਾਂ Google YouTube ਕੁਕੀ ਪਾਲਿਸੀ ਤੇ ਨੂੰ ਪੜ੍ਹਨਾ ਚਾਹੋਗੇ। ਇਸ ਸਮੱਗਰੀ ਨੂੰ ਦੇਖਣ ਲਈ ਇਜਾਜ਼ਤ ਦੇਵੋ ਤੇ ਜਾਰੀ ਰੱਖੋ ਨੂੰ ਚੁਣੋ।
End of YouTube post, 5
ਇਸ ਲੇਖ ਵਿੱਚ Google YouTube ਤੋਂ ਮਿਲੀ ਸਮੱਗਰੀ ਸ਼ਾਮਲ ਹੈ। ਕੁਝ ਵੀ ਡਾਊਨਲੋਡ ਹੋਣ ਤੋਂ ਪਹਿਲਾਂ ਅਸੀਂ ਤੁਹਾਡੀ ਇਜਾਜ਼ਤ ਮੰਗਦੇ ਹਾਂ ਕਿਉਂਕਿ ਇਸ ਵਿੱਚ ਕੁਕੀਜ਼ ਅਤੇ ਦੂਜੀਆਂ ਤਕਨੀਕਾਂ ਦਾ ਇਸਤੇਮਾਲ ਕੀਤਾ ਹੋ ਸਕਦਾ ਹੈ। ਤੁਸੀਂ ਸਵੀਕਾਰ ਕਰਨ ਤੋਂ ਪਹਿਲਾਂ Google YouTube ਕੁਕੀ ਪਾਲਿਸੀ ਤੇ ਨੂੰ ਪੜ੍ਹਨਾ ਚਾਹੋਗੇ। ਇਸ ਸਮੱਗਰੀ ਨੂੰ ਦੇਖਣ ਲਈ ਇਜਾਜ਼ਤ ਦੇਵੋ ਤੇ ਜਾਰੀ ਰੱਖੋ ਨੂੰ ਚੁਣੋ।
End of YouTube post, 6































